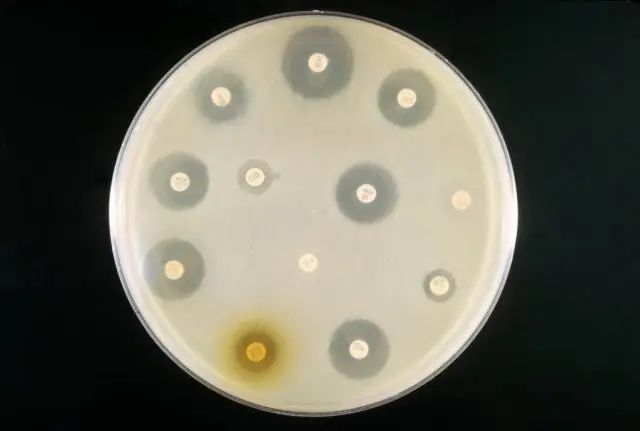
Взгляд на роль бактерий в недержании мочи

Мы все знаем это чувство внезапной потребности в мочеиспускании и мучительную тревогу, что мы можем не найти туалет вовремя или не успеть так далеко. К сожалению, для многих людей это обычное явление, и неконтролируемое обмывание - неизбежное последствие.
Почти 1 из 5 женщин старше 44 лет страдает так называемым неотложным недержанием мочи (УНМ): возникает сильное ощущение срочной потребности в мочеиспускании, за которым следует немедленная утечка большого объема мочи. Это может серьезно неблагоприятно повлиять на чью-то жизнь, способствуя беспокойству, депрессии и социальной изоляции.
Несмотря на его влияние, причины жалобы до сих пор относительно неизвестны. Это состояние часто связывают с аномальной сигнализацией, побуждающей мышцы мочевого пузыря непроизвольно сокращаться, но это, по-видимому, составляет лишь около трех пятых случаев. Ученые ищут другие возможные причины этого состояния. Некоторые думают, что понимание бактерий, которые живут внутри нас, может быть ключом к разгадке.
Долгое время считалось, что мочевыводящие пути являются стерильной средой: местом, где бактерии не могут размножаться. Новое исследование Орегонского университета здоровья и науки, опубликованное в Frontiers in Cellular and Infection Microbiology, предполагает, что это предположение может быть далеко от истины. Кроме того, их исследования показывают, что разнообразие и тип бактерий, присутствующих в тракте, могут играть роль в общем состоянии здоровья и таких состояниях, как срочное недержание мочи..
Основная причина, по которой мочевыводящие пути считаются негостеприимными для бактерий, заключается в том, что ученые не смогли вырастить бактерии из образцов мочи в лаборатории и поэтому полагали, что в этих образцах нет ничего живого. Однако команда из Орегона применила другой подход, ища контрольные признаки бактериальной ДНК в моче.
Почти у каждой женщины, у которой они собирали мочу, независимо от того, страдала она недержанием мочи или нет, присутствовал широкий спектр бактерий, хотя у женщин с недержанием мочи, по-видимому, было меньше различных типов бактерий. Рахель Нардос, один из ученых, стоящих за исследованием, надеется, что «научное сообщество сможет научиться понимать, как эти бактерии ведут себя в нормальных и болезненных условиях».
В некоторых случаях бактерии, присутствующие в моче женщин, страдающих НМН, относятся к тем же видам бактерий, которые вызывают инфекции мочевыводящих путей. Это говорит о том, что персистирующая инфекция низкой степени тяжести бактериями, которые обычно не выявляются при рутинных посевах, потенциально может быть причиной раздражающих симптомов НМН, по крайней мере, у некоторых людей. Рахель надеется, что «будущая работа в этой области исследований приведет к более точным диагнозам и лучшим целям для лечения»."
Кроме того, кажется, что чем меньше различных видов бактерий присутствует в мочевыводящих путях, тем тяжелее симптомы, испытываемые пациентом. Рахель считает, что «необходимо провести гораздо более масштабные исследования, чтобы понять… изменчивость этих бактериальных сообществ у здоровых людей и определить, существуют ли специфические закономерности, возникающие из этой изменчивости, которые указывают на нормальные и ненормальные состояния».
Медицина все больше признает, что в наших телах обитает целая экосистема бактерий и других микробов, которые добираются до нас автостопом, и что здоровье этой сети может влиять на наше самочувствие. Снижение микробного разнообразия других участков тела также было связано с различными клиническими состояниями, такими как ожирение, синдром раздраженного кишечника и воспалительное заболевание кишечника. Как говорит Рахель: «Оказывается, разнообразие полезно во всех аспектах жизни». Понимание сложностей бактерий в мочевыводящих путях может привести к ценному прогрессу в этой области.